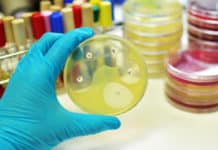
Researchers Develop Synthetic Polymer Capable of Vanquishing Superbugs

National Women Bioscientist Awards 2017-2018
National Women Bioscientist Awards 2017-2018
Apply for the DBT India National Women Bioscientist Awards 2017-2018. Notification is out for DBT National Women Bioscientist Awards 2017-2018. Check the...
Tata Innovation Fellowship 2017-18 For Life Sciences & Biotech
Tata Innovation Fellowship 2017-18 For Life Sciences & Biotech
Check the details on Tata Innovation Fellowship 2018. Official notification for Tata Innovation Fellowship 2017-18 is given...
Biotecnika Times – Newsletter 08.03.2018 – INSA Hiring Life Science Candidates
Biotecnika Times - INSA Hiring Life Science Candidates, Biocon Research
Life Sciences Job @ Indian National Science Academy With Rs. 40,000 pm Salary
Apply for Programme Associate...
Researchers Develop Synthetic Polymer Capable of Vanquishing Superbugs
Researchers Develop Synthetic Polymer Capable of Killing Superbugs
With no effective and safe treatments available, multidrug-resistant (MDR) infections are quickly morphing into a global healthcare...
Cell Cycle Regulation to Enable Cardiac Regeneration
Cell Cycle Regulation to Enable Cardiac Regeneration
Through normal wear and tear, our tissues experience regular cell loss that is countered by replenishment mechanisms. Aging...
Novel Biological Sample Storage Method Not Requiring Refrigeration Developed
Novel Biological Sample Storage Method Not Requiring Refrigeration Developed
Handling, transport, and storage of biospecimens such as blood and urine without refrigeration are extremely challenging....
Common Superbug Found to Exhibit “Heteroresistance” to Last-Resort Antibiotic
Common Superbug Found to Exhibit “Heteroresistance” to Last-Resort Ab
In a concerning find, scientists have now detected “heteroresistance” in the already highly resistant Klebsiella pneumoniae, a...
Geneticists Build World’s Biggest Family Tree Involving 13 Million People Across 11 Generations
Geneticists Build World’s Biggest Family Tree Involving 13 Million People Across 11 Generations
Family trees are mathematical graph structures that can capture mating and parenthood...
23andMe’s Direct-To-Consumer Genetic Cancer Risk Test Receives FDA Nod
23andMe's Direct-To-Consumer Genetic Cancer Risk Test - FDA Approved
The first direct-to-consumer DNA test for three BRCA1/BRCA2 breast cancer gene mutations has now received the federal...
IARI PhD Admissions 2018 – Official Notification
IARI PhD Admissions 2018 - Official Notification
Onine applications for phd programme at IARI. Indian Agricultural Research Institute Admissions Online Application process. Check all of...
National Bioscience Award for Career Development 2017-18
National Bioscience Award for Career Development 2017-18
Apply for the National Bioscience Award for Career Development 2017-18. Check details on the notification of National Bioscience...
Biotecnika Times – Newsletter 07.03.2018 – 350 Research Fellowship @ Merck
Biotecnika Times - 350 Research Fellowship @ Merck
CSIR NET – June 2018 Notification, Last Date to Apply & Eligibility
CSIR will hold the Joint CSIR-UGC...
Stem Cell-Aided Study of Alzheimer’s Proteins Points to New Therapeutic Approach
New Therapeutic Approach from Stem Cell-Aided Study of Alzheimer’s Proteins
The defining features of Alzheimer disease (AD) include conspicuous changes in both brain histology and behavior....
A Great Poo Patch Spotted from Space Leads to Discovery of Penguin “Super-Colony”
Patch Spotted from Space Leads to Discovery of Penguin “Super-Colony”
Monitoring populations is essential to species conservation, and can be used to identify threats or...
Urine Test to Determine Biological Age
Urine Test to Determine Biological Age
How old are you really?
It’s no surprise that ageing rates between individuals who share the same birth year can...